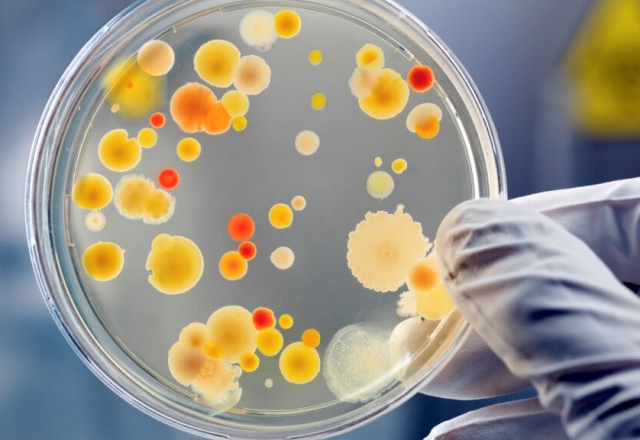
bacteria

Χρήσιμα Tips Καθαριότητας
Μέτρα πρόληψης κατά του κορωνοϊού
Έχοντας έρθει αντιμέτωποι με μία καινούρια πραγματικότητα λόγω του COVID-19, στην Glow φροντίσαμε την έγκαιρη και έγκυρη ενημέρωση του ανθρώπινου δυναμικού της εταιρείας.
Με τον τρόπο αυτό… περισσότερα
Σφουγγαρίστρες που σας κάνουν εύκολη την ζωή
Κλασική σφουγγαρίστρα Η κλασική σφουγγαρίστρα φτιάχνεται από βαμβάκι και συνήθως είναι κατάλληλη για εξωτερικούς χώρους, όπως είναι το μπαλκόνι. Έχει ένα βασικό μειονέκτημα πως μπορεί να αφήσει μικρά… περισσότερα
Αποφυγή Μικροβίων - Γιατί Πρέπει να Ανησυχούμε Περισσότερο για την Κουζίνα Αντί για το Μπάνιο.
Στην πλειονότητα του κόσμου έχει περάσει η άποψη ότι η τουαλέτα πρέπει να είναι πάντα καθαρή και για αυτό το λόγο συνήθως ο χώρος αυτός είναι πάντα σε πολύ καλή κατάσταση. Η κουζίνα όμως είναι εξίσου… περισσότερα
Αυτά Είναι τα 5 Μέρη του Σπιτιού με την Περισσότερη Σκόνη
Υπάρχουν μερικά σημεία του σπιτιού που μαζεύουν πολύ περισσότερη σκόνη από άλλα. Δείτε ποια είναι αυτά και πώς να τα καθαρίσετε με ελάχιστες κινήσεις.
Βιβλιοθήκες. Τις περισσότερες φορές δεν… περισσότερα
Σπίτι που Μοσχομυρίζει Συνέχεια
Κάθε σπίτι έχει το δικό του άρωμα, τη δική του μυρωδιά. Κάποια μυρίζουν καλύτερα από άλλα. Μπορεί να είναι δύσκολο να κρατήσετε την ωραία μυρωδιά ενός σπιτιού που έχει πρόσφατα καθαριστεί σε βάθος,… περισσότερα